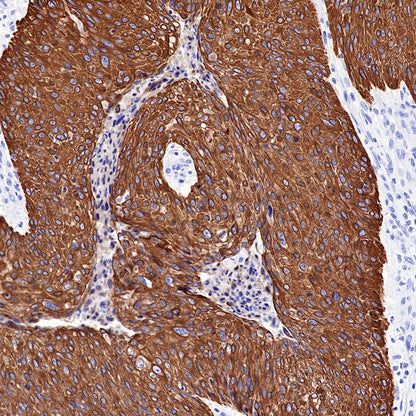
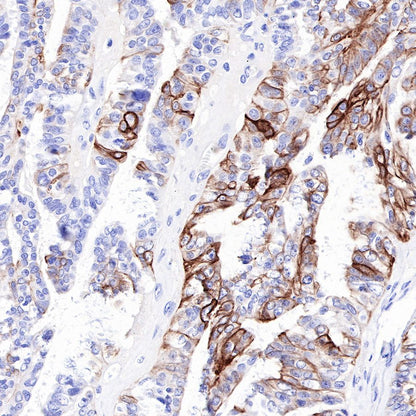

Product Specification
| Host |
Rabbit |
| Antigen |
CK-HMW |
| Synonyms |
Cytokeratin HMW, Keratin HMW |
| Immunogen |
N/A |
| Location |
Cytoplasm |
| Clone Number |
SDT-P002 |
| Antibody Type |
Rabbit mAb |
| Application |
WB, IHC-P, IF |
| Reactivity |
Hu |
| Purification |
Protein A |
| Concentration |
0.13 mg/ml |
| Physical Appearance |
Liquid |
| Storage Buffer |
PBS, 40% Glycerol, 0.05%BSA, 0.03% Proclin 300 |
| Stability & Storage |
12 months from date of receipt / reconstitution, -20 °C as supplied |
Dilution
| application |
dilution |
species |
| WB |
1:500 |
null |
| IHC-P |
1:1000 |
null |
| IF |
1:500 |
null |
Background
CK (HMW) is a high molecular weight cytokeratin. Expressed in squamous epithelium, ductal epithelium, stratified epithelium, prostate basal cells, and breast myoepithelial cells.It is a specific marker for prostate basal cells and it combined with p63 and AMACR for diagnosis of benign and malignant prostate lesions. It can also be used to differentiate urothelium dysplasia and carcinoma in situ.